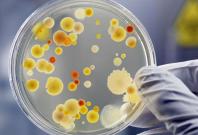
coronavirus farts in petri dish coronavirus farts in petri dish

United States


Ryan Reynolds, Hugh Jackman pause fun feud for COVID-19 relief

US newspapers now employ half the scribes it had a decade ago

Restaurants, churches and few schools to reopen from May 15 in Austria amid Coronavirus crisis

Coronavirus most likely of animal origin and not laboratory made: WHO

Coronavirus: Pastor from Louisiana under scrutiny again for attacking a protester outside the church

Newspapers in US mark increase in pages of obituaries amid Coronavirus crisis

Coronavirus death toll due to the Coronavirus in UK is 41% higher than the data suggested: Report

Amnesty says Saudi Arabia executed record number of people in 2019 even as global executions declined
Apr 21, 2020
By Gani Mohamed Waseem

World hunger may double due to the Coronavirus blow: UN
Experts suggest 'No bare-bottom farting' as people fear Coronavirus spread through farts

Gender-based violence rising amid COVID-19 pandemic: Study

NZ further extends state of national emergency

Who is Yumi Hogan? The hand behind Maryland obtaining Coronavirus testing kits from South Korea
